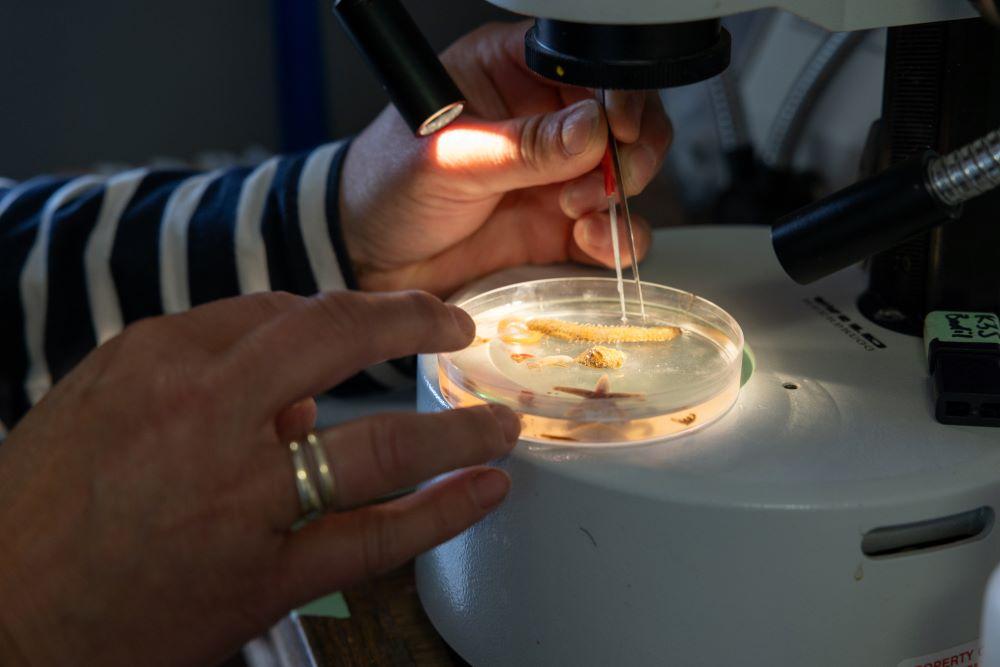

In partnership met Rolex
Rolex en National Geographic lanceren een nieuwe serie expedities. De komende twee jaar zullen de Rolex National Geographic Perpetual Planet Ocean Expeditions de wereldzeeën onderzoeken. Ze combineren academische wetenschap met lokale ecologische kennis om de grootste ecosystemen op aarde – de oceanen – te beschermen en te herstellen.
Nieuwe inzichten in kwetsbare gebieden

Rolex en National Geographic Society besloten in 2019 om kwetsbare gebieden te exploreren via de Perpetual Planet Expeditions. Dankzij wetenschappelijke expertise en avant-gardetechnologie verschaffen de expedities nieuwe inzichten in de impact van de klimaatverandering op de vitale systemen van de aarde: de bergen als de watertorens van de wereld, de regenwouden als de longen van de planeet, de oceanen als het koelingssysteem.
Weerstations op de Mount Everest

Het partnerschap tussen Rolex en National Geographic leidde al in 2019 tot een eerste expeditie. Op de Mount Everest werd de invloed van de klimaatverandering op de gletsjers van de Himalaya onderzocht. De gletsjers zijn belangrijke waterbronnen voor een miljard mensen. Het team installeerde vijf weerstations, waaronder het op dat moment hoogste weerstation van de wereld, vlak onder de top van de Mount Everest. Het onderzoek van de biologie, geologie en glaciologie van de regio leverde een aantal wetenschappelijke publicaties op.
De expeditie naar de Andes

Twee jaar later plaatste een team van National Geographic Explorers het toen hoogste weerstation in de zuidelijke en westelijke hemisfeer: dicht bij de top van de Tupungato, een vulkaan op de grens tussen Chili en Argentinië. Daardoor kreeg de wetenschap zicht op de atmosferische processen in hooggebergte van de Andes. De bergen daar leveren zuiver water aan de meer dan zes miljoen van het nabije Santiago.
Het diepste ijs uit Canada

Nog in 2021 beklommen glacioloog Alison Criscitiello en geoloog Rebecca Haspel in Canada de Mount Logan, de op één na hoogste berg in Noord-Amerika. Ze zetten er een weerstation neer en keerden een jaar later terug om ijslaag van 327 meter diep – een recorddiepte – naar boven te halen. Dit ‘diepe’ ijs bevat informatie over duizenden jaren van klimaatverandering.
De nuttige overstromingen van de Amazone
In april 2022 lanceerden Rolex en National Geographic voor de volgende twee jaar een serie van wetenschappelijke studies die het volledige bekken van de Amazone – van de Andes tot de Atlantische Oceaan – overspanden. De rivier heeft te lijden onder ontbossing, stroperij, commerciële landbouw en klimaatverandering. Een team van wetenschappers, storytellers en leden van de lokale gemeenschap toonde aan hoe het Amazonegebied functioneerde volgens een ingewikkeld systeem van connectiviteit. In de hydrologische cyclus van de regio spelen de aan het regenseizoen verbonden overstromingen van de Amazone een cruciale rol. Ze zijn belangrijk voor de toegang tot zuiver water en de overleving van lokale gemeenschappen en wildlife.
Water bedekt bijna driekwart van het aardoppervlak

Rolex en National Geographic kondigden in juni een nieuwe serie van expedities aan. De komende twee jaar onderzoeken de Rolex and National Geographic Perpetual Planet Ocean Expeditions, van kust tot zeebodem en van pool tot pool, de vijf oceanen op aarde.
Onze zeeën bedekken bijna driekwart van het aardoppervlak en leveren een wezenlijke bijdrage in de biodiversiteit op aarde. Toch is momenteel slechts 8 procent van het blauwe hart van de planeet beschermd. Ondanks hun grootte zijn onze oceanen kwetsbaar. Nu de temperatuur van de oceanen stijgt, waardoor hele ecosystemen worden bedreigd, is het belangrijker dan ooit om actie te ondernemen en de zeeën te beschermen. Meer dan 100 landen stemden toe om 30 procent te beschermen tegen 2030.
Het goede voorbeeld van het Sherman Basin

Een eerste project van de Rolex and National Geographic Perpetual Planet Ocean Expeditions mikt op een beter begrip van het Sherman Basin. Dit waterbekken ligt in Canada, meer bepaald in de Kitikmeot Zee, in het zuiden van de Arctische Oceaan. Het is een uniek en dynamisch estuarium dat grote hoeveelheden zoet water ontvangt uit rivieren, zout en voedselrijk water uit diepe oceaanstromingen, en een sterk stromingsregime kent door de getijden in smalle zeestraten. Sherman Basin staat bekend om zijn biologische overvloed en zijn weerstand tegen klimaatverandering. In samenwerking met de lokale gemeenschap van Gjoa Haven wil de expeditie informatie verzamelen, bijvoorbeeld over voedselzekerheid, die andere arctische regio’s in verandering kan beschermen.
Op de bodem van de ijszee

Een andere expeditie verkent in de Zuidelijke Oceaan de bodem van de ijszee. Hoe de klimaatverandering daar de ecosystemen beïnvloedt, werd nooit eerder bestudeerd. De National Geographic Explorers genieten er assistentie van het Schmidt Ocean Institute. Dat reikt state-of-the-art-toestellen aan, én de R/V Falkor, een ultramodern oceanografisch onderzoeksschip.
De vissers van de Seychellen

In de Indische Oceaan bundelen een National Geographic Explorer en een lokale medewerker de krachten om in de Seychellen biodiverse en overvloedige visgronden te beschermen. Ze plaatsen er op maat gemaakte diepzeecamera’s waarmee ze belangrijke data verzamelen die het visserijbeleid mee helpen te sturen en de kans vergroten om de lokale ecosystemen te behouden. Het is de eerste lokaal geleide expeditie.
Steun voor de koralen

Intussen, in een poging om nuttige informatie te bezorgen voor de restauratie van de koraalriffen in Rarotonga (een van de Cookeilanden) in de Stille Oceaan, willen National Geographic Explorers innovatieve methoden ontwikkelen waarmee ze de tolerantie van de koralen voor de opwarmende temperatuur van de zee kunnen boosten.
De mangroves van Gambia

In de Atlantische Oceaan bestuderen National Geographic Explorers de mangroves van Gambia. Door de stijging van het oceaanpeil dringt zout water in de rivier, waardoor landbouwland in onbruik raakt. Dit bedreigt de kustgemeenschappen van de Bintang Bolong, inbegrepen de hoofdstad Banjul. In de monding van de Gambia Rivier wordt onderzocht welke rol de mangroves spelen op het vlak van biodiversiteit en voedselzekerheid en hoe die beschermende bijdrage kan worden behouden en versterkt.
Platformen voor hulp

De National Geographic Explorers en de lokale gemeenschappen krijgen de hulp van diepzeeonderzoeker Katy Croff Bell. Op elke Perpetual Planet Ocean Expedition wil ze één van haar twee of beide platformen inzetten: Maka Niu en DORIS (Deep Ocean Research and Imaging System). De platformen maken laagdrempelig en aan lage kosten gebruik van diepzeecamera’s en -sensoren. Met haar platformen breidt Croff Bell de toegang tot het onderzoek van zeediepten uit.

Rolex steunt personen en organisaties die voor de problemen van de planeet oplossingen zoeken en ontwikkelen en die zo bijdragen tot het verbeteren van de wereld en bewaren van de planeet voor de volgende generaties. In deze serie zet Knack deze inspanningen in de kijker. Knack realiseerde die verhalen in volle redactionele onafhankelijkheid.
Ontdek hier het vorige artikel uit de serie: Sylvia Earle, de heldin van de oceaan